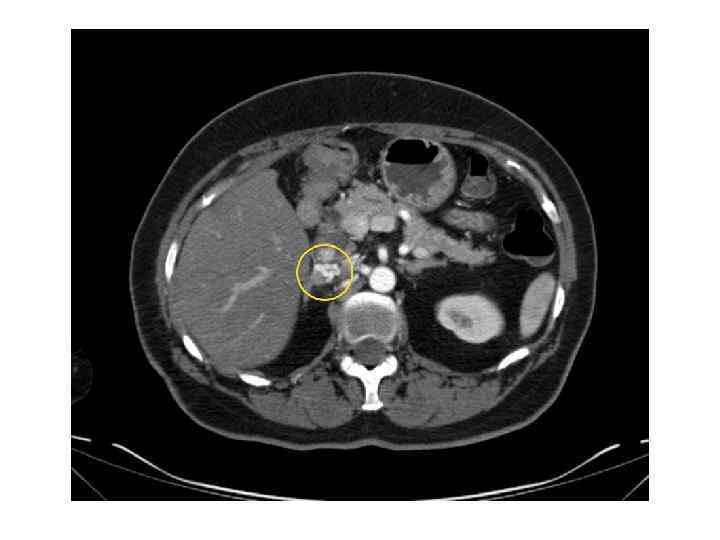

Опухоли надпочечников(Бобков Д.).ppt
- Количество слайдов: 26

Опухоли коры надпочечников Студент: Бобков Даниил Николаевич, 5 курса лечебного факультета ПМГМУ им. И. М. Сеченова Руководитель: Моргунова Татьяна Борисовна, к. м. н. , доцент кафедры Эндокринологии Москва 2016

Анатомия и физиология надпочечников Надпочечник • парная железа внутренней секреции, расположенная в забрюшинном пространстве над верхним полюсом почки (на уровне XI-XII грудных позвонков). Мозговое и корковое вещество функционально независимы.


Классификация Гистологическая классификация опухолей коры надпочечников: ✧ Доброкачественные: – Аденома коры надпочечника. – Пигментированная ( «черная» ) аденома. – Онкоцитарная аденома. ✧ Злокачественные: – Адренокортикальная карцинома (рак коры надпочечников). – Карциносаркома надпочечника.

Классификация (2) • Гормонально-неактивные (около 70%) • Гормонально-активные образования коры надпочечников: 1) Кортикостерома 2) Альдостерома 3) Андрогенпродуцирующая опухоль, секреция ДГЭА-сульфата 4) Эстрогенпродуцирующая опухоль

Инциденталома • Инциденталома – образование надпочечника (ОНП), выявленное при визуализирующем обследовании не по поводу патологии надпочечников, а в связи с другими причинами • В каждом случае выявления ОНП должна рассматриваться вероятность наличия его гормональной активности и злокачественного потенциала

Эпидемиология • По данным аутопсийных исследований распространенность инциденталом составляет 1, 4— 8, 7% • Большинство выявляемых образований составляли опухоли небольших размеров. Распространенность образований более 1, 5 см составляет 1, 8%, а доля образований более 6 см— 0, 025%. • По данным компьютерной томографии (КТ) случайные ОНП выявляются у 0, 6— 4, 4% обследованных пациентов, 79% из них – менее 2 см • Отмечается увеличение числа выявления ОНП с возрастом пациентов — среди лиц старше 50 лет их частота составляет 3— 7%, тогда как у обследованных до 30 лет только 0, 2%. • Двусторонние ОНП встречаются в 2— 10% всех случаев «Инциденталома надпочечника. Методические рекомендации для врачей первичного звена» под редакцией Дедова И. И. , Мельниченко Г. А.

Диагностика • Методы визуализации надпочечников: 1) КТ 2) МРТ 3) ПЭТ 4) Ультразвуковое исследование • Клиническая картина • Гормональное обследование • Пункционная биопсия

КТ и МРТ признаки ДОНП АКР Метастаз Размер < 3 см > 4 см < 3 см (обычно) Форма Округлая, четкий контур Неправильная, нечеткий контур Овальная; нечет- кий, прерывистый контур Сторона выявления Одиночная или двусторонняя Чаще двусторонний Рост < 1 см в год > 2 см в год Различный Структура Гомогенная Гетерогенная, с участками различной плотности Гетерогенная с участками различной плотности

КТ и МРТ признаки (2) ДОНП АКР Метастаз < 10 HU >10 -25 HU Васкуляризация в контрастную фазу + + Изменение плотности через 10 минут выведения контраста >50% <50% Некрозы, кальцинаты, кровоизлияния Редко Часто Не всегда Неконтрастная плотность «Инциденталома надпочечника. Методические рекомендации для врачей первичного звена» под редакцией Дедова И. И. , Мельниченко Г. А.

Адренокортикальный рак • Несмотря на то, что рак НП встречается редко, его течение крайне агрессивное и прогноз неблагоприятен. • Функционально-активные карциномы выявляются у 62% пациентов с АКР. • Наиболее частое проявление гормональной активности – гиперкортицизм, встречаются симптомы смешанной гормональной активности. • Для оценки вероятности АКР используется два параметра: размер опухоли и ее радиологическая семиотика. • АКР составляет около 2% случаев среди опухолей размерами до 4 см, 6% среди опухолей 4, 1– 6 см и 25% среди опухолей более 6 см. • На сегодняшний день продолжительность жизни больных с АКР после хирургического лечения составляет менее 50% за 5 лет

Метастатическая карцинома • Метастатическая карцинома выявляется у половины пациентов с инциденталомами, у которых в анамнезе рак иной локализации. • Наиболее часто метастазируют в надпочечник опухоли легкого, почки, толстой кишки, молочных желез, пищевода, поджелудочной железы, печени и желудка. • Надпочечниковые метастазы часто бывают двусторонними. • Как правило, к моменту выявления метастатической карциномы надпочечника первичный очаг рака известен. • В противном случае рекомендовано проведение ПЭТ с 18 F-ФДГ

Кортикостерома • Доброкачественная опухоль коры НП, является вариантом эндогенного АКТГ- независимого гиперкортицизма (синдром Иценко-Кушинга) • Субклинический вариант – у 5 -20% больных с инциденталомами

Клиническая картина 1. Диспластическое ожирение 2. Трофические изменения кожных покровов, появление багровых стрий 3. Артериальная гипертензия, тахикардия 4. Вторичный гипогонадизм 5. Нарушение углеводного обмена 6. Миопатия 7. Гипокалиемия, гипернатриемия 8. Вторичный иммунодефицит 9. Системный остеопороз 10. Гиперпигментация кожных покровов


Диагностика Клинические проявления гиперкортицизма Определение содержания свободного кортизола в суточной моче Малый дексаметазоновый тест Определение ритма инкреции кортизола (определение содержания кортизола в ночные часы) Синдром гиперкортицизма Псевдокушингоидные состояния Исследование содержания АКТГ <10 нг/мл или ниже референтных значений >10 нг/мл, в пределах или выше референтных значений КТ/МРТ надпочечников Большая дексаметазоновая проба Первичное поражение надпочечников Критерии для болезни Иценко-Кушинга Эндокринология. Национальное руководство. Краткое издание. Под ред. И. И. Дедова, Г. А. Мельниченко. — М. : ГЭОТАР-Медиа, 2013 – стр. 491

Альдостерома • У 50– 70% пациентов вследствие дистрофических изменений почечных канальцев, нефросклероза на фоне АГ и межуточного воспаления интерстиция почки на фоне гипокалиемии ( «гипокалиемическая почка» ) наблюдается никтурия, полиурия, гипоизостенурия • В 35– 75% случаев у пациентов может наблюдаться гипокалиемия, проявляющаяся мышечной слабостью, парезами, парестезиями и судорогами.

Диагностика • Гормональное обследование – при наличии АГ • При наличии АГ – определение альдостеронренинового соотношения (АРС) • При положительном АРС – дальнейшее обследование одним из четырех подтверждающих тестов: 1) С пероральной натриевой нагрузкой 2) Инфузионный тест с физ. р-ром 3) Подавляющий тест с флудрокортизоном 4) Тест с каптоприлом

Андростерома • Исследование ДГЭА-сульфата (однако важно помнить о том, что ДГЭА-сульфат нередко повышен при АКР) • Развитие признаков вирилизации у женщин

Кортикоэстрома • Часто возникают у детей • Наиболее частым симптомом заболевания у мужчин является гинекомастия, наблюдаемая в 98% случаев. Развивается атрофия яичек, снижается либидо и потенция, уменьшается рост бороды и усов. • Диагностическими критериями является сниженный уровень гонадотропинов на фоне высокой секреции эстрагенов

Лечение • Хирургическое лечение (гормональная активность, размеры > 6 см, АКР) • Динамическое наблюдение (КТ через 6, 12, 24 месяцев после первичного выявления) • Исключение гормональной активности – не менее 4 лет после первичного выявления «Эндокринная хирургия» / Под ред. Дедова И. И. , Кузнецова Н. С. , Мельниченко Г. А. – М. : Литтерра, 2011


Спасибо за внимание!
Опухоли надпочечников(Бобков Д.).ppt